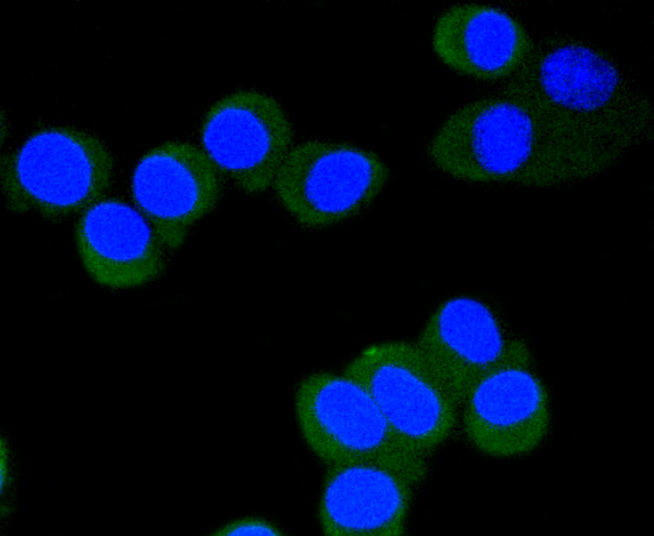

Lane 1: Mouse spleen; Lane 2: Rat spleen cell lysate probed with eIF4E(S209) (2B1) Monoclonal Antibody (bsm-52152R) at 1:1000 overnight at 4˚C. Followed by a conjugated secondary antibody.
phospho-eIF4E (Ser209) Recombinant Antibody
BSM-52152R
ApplicationsImmunoFluorescence, Western Blot, ImmunoCytoChemistry, ImmunoHistoChemistry, ImmunoHistoChemistry Frozen, ImmunoHistoChemistry Paraffin
Product group Antibodies
TargetEIF4E
Overview
- SupplierBioss
- Product Namephospho-eIF4E (Ser209) Recombinant Antibody
- Delivery Days Customer16
- ApplicationsImmunoFluorescence, Western Blot, ImmunoCytoChemistry, ImmunoHistoChemistry, ImmunoHistoChemistry Frozen, ImmunoHistoChemistry Paraffin
- Applications SupplierWB(1:300-5000), IHC-P(1:200-400), IHC-F(1:100-500), IF(), ICC/IF(1:50-100)
- CertificationResearch Use Only
- ClonalityMonoclonal
- Concentration1 ug/ul
- ConjugateUnconjugated
- Gene ID1977
- Target nameEIF4E
- Target descriptioneukaryotic translation initiation factor 4E
- Target synonymsAUTS19, CBP, EIF4E1, EIF4EL1, EIF4F, eIF-4E, eukaryotic translation initiation factor 4E, eIF-4F 25 kDa subunit, eukaryotic translation initiation factor 4E-like 1, mRNA cap-binding protein
- HostRabbit
- IsotypeIgG
- Protein IDP06730
- Protein NameEukaryotic translation initiation factor 4E
- Storage Instruction-20°C
- UNSPSC12352203